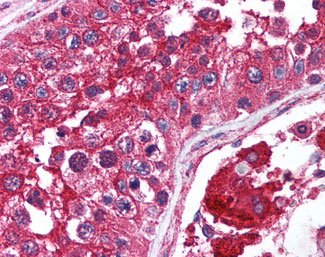

> Antigen, Antibodies, ELISA, Western Blot > Primary Antibody > Polyclonal Antibodies > MTOR Antibody (aa2440-2457)Brand |
Leading Biology | Catalog Number |
APR08558G |
Product Type |
Polyclonal Antibodies | Field of Research |
|
Product Overview |
We constantly strive to ensure we provide our customers with the best antibodies. As a result of this work we offer this antibody in purified format.
We are in the process of updating our datasheets. If you have any questions regarding this update, please feel free to contact our technical support team.
This product is a high quality MTOR antibody (aa2440-2457).
|
||
Molecular Weight |
289kDa
|
||
Cellular Localization |
Antigen Cellular Localization:
Endoplasmic reticulum membrane; Peripheral membrane protein; Cytoplasmic side. Golgi apparatus membrane; Peripheral membrane protein; Cytoplasmic side. Mitochondrion outer membrane; Peripheral membrane protein; Cytoplasmic side. Lysosome Cytoplasm. Nucleus, PML body Note=Shuttles between cytoplasm and nucleus. Accumulates in the nucleus in response to hypoxia (By similarity). Targeting to lysosomes depends on amino acid availability and RRAGA and RRAGB
|
||
Host |
Rabbit
|
||
Species Reactivity |
Human, Mouse, Rat
|
||
Target |
Amino acids 2440-2457 of human mTOR.
|
||
Symbol |
FRAP, FRAP1, FRAP2, RAFT1, RAPT1
|
||
GeneID |
|||
UniProt ID |
|||
Function |
Serine/threonine protein kinase which is a central regulator of cellular metabolism, growth and survival in response to hormones, growth factors, nutrients, energy and stress signals. MTOR directly or indirectly regulates the phosphorylation of at least 800 proteins. Functions as part of 2 structurally and functionally distinct signaling complexes mTORC1 and mTORC2 (mTOR complex 1 and 2). Activated mTORC1 up-regulates protein synthesis by phosphorylating key regulators of mRNA translation and ribosome synthesis. This includes phosphorylation of EIF4EBP1 and release of its inhibition toward the elongation initiation factor 4E (eiF4E). Moreover, phosphorylates and activates RPS6KB1 and RPS6KB2 that promote protein synthesis by modulating the activity of their downstream targets including ribosomal protein S6, eukaryotic translation initiation factor EIF4B, and the inhibitor of translation initiation PDCD4. Stimulates the pyrimidine biosynthesis pathway, both by acute regulation through RPS6KB1- mediated phosphorylation of the biosynthetic enzyme CAD, and delayed regulation, through transcriptional enhancement of the pentose phosphate pathway which produces 5-phosphoribosyl-1- pyrophosphate (PRPP), an allosteric activator of CAD at a later step in synthesis, this function is dependent on the mTORC1 complex. Regulates ribosome synthesis by activating RNA polymerase III-dependent transcription through phosphorylation and inhibition of MAF1 an RNA polymerase III-repressor. In parallel to protein synthesis, also regulates lipid synthesis through SREBF1/SREBP1 and LPIN1. To maintain energy homeostasis mTORC1 may also regulate mitochondrial biogenesis through regulation of PPARGC1A. mTORC1 also negatively regulates autophagy through phosphorylation of ULK1. Under nutrient sufficiency, phosphorylates ULK1 at 'Ser- 758', disrupting the interaction with AMPK and preventing activation of ULK1. Also prevents autophagy through phosphorylation of the autophagy inhibitor DAP. mTORC1 exerts a feedback control on upstream growth factor signaling that includes phosphorylation and activation of GRB10 a INSR-dependent signaling suppressor. Among other potential targets mTORC1 may phosphorylate CLIP1 and regulate microtubules. As part of the mTORC2 complex MTOR may regulate other cellular processes including survival and organization of the cytoskeleton. Plays a critical role in the phosphorylation at 'Ser-473' of AKT1, a pro-survival effector of phosphoinositide 3-kinase, facilitating its activation by PDK1. mTORC2 may regulate the actin cytoskeleton, through phosphorylation of PRKCA, PXN and activation of the Rho-type guanine nucleotide exchange factors RHOA and RAC1A or RAC1B. mTORC2 also regulates the phosphorylation of SGK1 at 'Ser-422'.
|
||
Summary |
Serine/threonine protein kinase which is a central regulator of cellular metabolism, growth and survival in response to hormones, growth factors, nutrients, energy and stress signals. MTOR directly or indirectly regulates the phosphorylation of at least 800 proteins. Functions as part of 2 structurally and functionally distinct signaling complexes mTORC1 and mTORC2 (mTOR complex 1 and 2). Activated mTORC1 up-regulates protein synthesis by phosphorylating key regulators of mRNA translation and ribosome synthesis. This includes phosphorylation of EIF4EBP1 and release of its inhibition toward the elongation initiation factor 4E (eiF4E). Moreover, phosphorylates and activates RPS6KB1 and RPS6KB2 that promote protein synthesis by modulating the activity of their downstream targets including ribosomal protein S6, eukaryotic translation initiation factor EIF4B, and the inhibitor of translation initiation PDCD4. Stimulates the pyrimidine biosynthesis pathway, both by acute regulation through RPS6KB1- mediated phosphorylation of the biosynthetic enzyme CAD, and delayed regulation, through transcriptional enhancement of the pentose phosphate pathway which produces 5-phosphoribosyl-1- pyrophosphate (PRPP), an allosteric activator of CAD at a later step in synthesis, this function is dependent on the mTORC1 complex. Regulates ribosome synthesis by activating RNA polymerase III-dependent transcription through phosphorylation and inhibition of MAF1 an RNA polymerase III-repressor. In parallel to protein synthesis, also regulates lipid synthesis through SREBF1/SREBP1 and LPIN1. To maintain energy homeostasis mTORC1 may also regulate mitochondrial biogenesis through regulation of PPARGC1A. mTORC1 also negatively regulates autophagy through phosphorylation of ULK1. Under nutrient sufficiency, phosphorylates ULK1 at 'Ser- 758', disrupting the interaction with AMPK and preventing activation of ULK1. Also prevents autophagy through phosphorylation of the autophagy inhibitor DAP. mTORC1 exerts a feedback control on upstream growth factor signaling that includes phosphorylation and activation of GRB10 a INSR-dependent signaling suppressor. Among other potential targets mTORC1 may phosphorylate CLIP1 and regulate microtubules. As part of the mTORC2 complex MTOR may regulate other cellular processes including survival and organization of the cytoskeleton. Plays a critical role in the phosphorylation at 'Ser-473' of AKT1, a pro-survival effector of phosphoinositide 3-kinase, facilitating its activation by PDK1. mTORC2 may regulate the actin cytoskeleton, through phosphorylation of PRKCA, PXN and activation of the Rho-type guanine nucleotide exchange factors RHOA and RAC1A or RAC1B. mTORC2 also regulates the phosphorylation of SGK1 at 'Ser-422'.
|
||
Form |
Liquid |
||
Storage & Stability |
Store at +4°C short term. For long-term storage, aliquot and store at -20°C or below. Stable for 12 months at -20°C. Avoid repeated freeze-thaw cycles.
|
||
Applications |
WB, IHC-P, IF, E
|
||
Dilution |
ELISA (1:4000-1:20000), IHC-P (2.5 μg/ml), WB (1:250-1:2000)
|
||
Synonyms |
Serine/threonine-protein kinase mTOR, 2.7.11.1, FK506-binding protein 12-rapamycin complex-associated protein 1, FKBP12-rapamycin complex-associated protein, Mammalian target of rapamycin, mTOR, Mechanistic target of rapamycin, Rapamycin and FKBP12 target 1, Rapamycin target protein 1, MTOR, FRAP, FRAP1, FRAP2, RAFT1, RAPT1
|
||
Images |

Anti-MTOR antibody IHC of human prostate.
Anti-MTOR antibody IHC of human testis. 
Anti-mTOR Antibody - Western Blot. |
||
Specification |
|||
Quantity |
|
||
| Select | Brand | Catalog No. | Product Name | Pack Size | Type | Field of Research | Specification | Quantity | Price(USD) | |
| 1 | Leading Biology | APR03440G | ITGA11 Antibody (N-term) | 100 μl | Polyclonal Antibodies |
|
$495.00 | Add Ask | ||
| 2 | Leading Biology | APR04537G | CMIP Antibody (C-term) | 100 μl | Polyclonal Antibodies |
|
$495.00 | Add Ask | ||
| 3 | Leading Biology | APR12422G | Human H4 Histamine Receptor (extracellular) Antibody | 50 μl | Polyclonal Antibodies |
|
$695.00 | Add Ask | ||
| 4 | Leading Biology | APR03844G | UBE2W Antibody (C-term) | 100 μl | Polyclonal Antibodies |
|
$495.00 | Add Ask | ||
| 5 | Leading Biology | APR04349G | HECTD2 Antibody (N-term) | 100 μl | Polyclonal Antibodies |
|
$495.00 | Add Ask | ||
| 6 | Leading Biology | APR03502G | IGHG1 Antibody (Center) | 100 μl | Polyclonal Antibodies |
|
$495.00 | Add Ask |
 Leading Biology Inc.
2600 Hilltop DR, Building G, B Suite C138
Richmond, CA, 94806
Tel: 1-661-524(LBI)-0262
Email: info@leadingbiology.com
Leading Biology Inc.
2600 Hilltop DR, Building G, B Suite C138
Richmond, CA, 94806
Tel: 1-661-524(LBI)-0262
Email: info@leadingbiology.com
Complete this form and click send to ask us a question, request a quote or simply say hello.

You have 0 item in your cart

You have 0 item in your inquiry list
